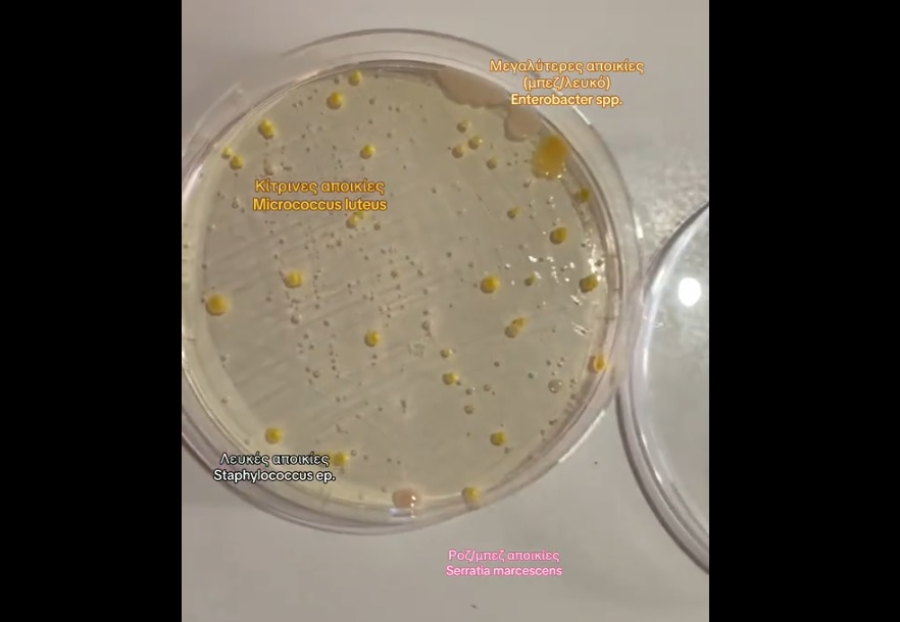
«Παρέλαση» μικροβίων στο μετρό της Αθήνας - Ελληνίδα βιολόγος αποκαλύπτει τι εντόπισε

Τα μέσα μαζικής μεταφοράς, και ιδιαίτερα το μετρό, χρησιμοποιούνται καθημερινά από εκατομμύρια ανθρώπους για τις μετακινήσεις τους, είτε προς την εργασία τους είτε για άλλους λόγους.
Όπως είναι αναμενόμενο, η συχνή χρήση του μετρό οδηγεί στη συγκέντρωση μικροβίων σε διάφορες επιφάνειες. Μια μικροβιολόγος, θέλοντας να διερευνήσει το επίπεδο μικροβιακής επιβάρυνσης, συνέλεξε δείγματα από επιφάνειες του μετρό χρησιμοποιώντας μια μπατονέτα.
Σε βίντεο που δημοσίευσε στο TikTok, αποκάλυψε ότι εντόπισε αποικίες μικροβίων σε διάφορα χρώματα—ροζ, λευκές, κίτρινες και μεγαλύτερες μπεζ—με μία εξ αυτών να περιέχει σταφυλόκοκκο.
Οι χρήστες στα σχόλια αντέδρασαν με ανησυχία, με πολλούς να δηλώνουν ότι θα είναι πιο προσεκτικοί στο μέλλον σχετικά με το τι αγγίζουν κατά τις μετακινήσεις τους.
Τι βρέθηκε η βιολόγος στο μετρό
• Micrococcus luteus
Συχνά βρίσκεται σε επιφάνειες που αγγίζουμε καθημερινά. Συνήθως αβλαβές, αλλά σε ανοσοκατεσταλμένα άτομα μπορεί να προκαλέσει ευκαιριακές λοιμώξεις
•Staphylococcus epidermidis
Αποτελεί μέρος της φυσιολογικής χλωρίδας του δέρματος και των βλεννογόνων. Είναι συχνό αίτιο νοσοκομειακών λοιμώξεων.
•Enterobacter spp.
Υπάρχει φυσιολογικα στο γαστρεντερικό σύστημα ανθρώπων και ζώων, στο έδαφος και το νερό. Προκαλεί λοιμώξεις του ουροποιητικού και αναπνευστικού
•Serratia marcescens
Εμφανίζεται συχνά σε μπάνια, νιπτήρες και νοσοκομεία. Μπορεί να προκαλέσει λοιμώξεις του ουροποιητικού και αναπνευστικού.